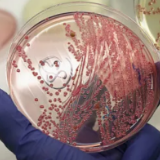
美国已累计报告84例大肠杆菌感染者 快餐巨头温蒂汉堡配合调查

美国疾控中心25日表示,与美国快餐巨头温蒂汉堡有关的大肠杆菌感染本周继续在美国中西部扩大。自本月17日首次公布以来,已累计报告相关感染人数达84人,不过,暂无人员死亡的报告。
美国广播公司报道称,美疾控中心已接到来自4个州的相关病例报告。分别为:密歇根州53例,俄亥俄州23例,印第安纳州6例,以及宾夕法尼亚州2例。目前,美疾控中心正努力确认污染源。但接受调查的84%的患者都表示,他们在出现症状的前一周都曾在温蒂汉堡用餐。另有88%的受访患者说,他们在温蒂汉堡食用过带罗马生菜的汉堡或是三明治。
对此,温蒂汉堡已于上周五发表声明称,他们正全力配合调查。同时,为预防感染事件的进一步扩大,所在区域的部分餐厅已清空了之前罗马生菜的相关库存,并对三明治里的罗马生菜进行了替换。但温蒂汉堡强调,他们在沙拉里所使用的生菜是不同的,且不受本次更换材料的影响。
截至目前,美疾控中心还没有建议民众不要在温蒂汉堡用餐,也没有建议人们不要食用罗马生菜。但美疾控中心警告称,大多数感染大肠杆菌的患者在摄入大肠杆菌三到四天后,便会开始出现严重的胃痉挛、呕吐和急性腹泻等症状。如果症状严重,应立即就医。
来源:央视财经
编辑:姜媚
本文链接:https://news.rednet.cn/content/2022/08/28/11762733.html